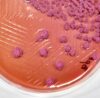

Melioidosis is a potentially fatal infectious disease caused by Burkholderia pseudomallei, a saprophytic Gram-negative bacteria found majorly in soil. The increasing number of melioidosis cases suggest an emerging trend but a seemingly neglected nature of the disease, especially in India.
A recent modelling study predicted that the number of cases in South Asia is higher than those from other endemic countries due to high population density and the prevalence of multiple comorbid factors.
A recent modelling study predicted that the number of cases in South Asia is higher than those from other endemic countries due to high population density and the prevalence of multiple comorbid factors.
Additionally, the lack of definitive treatment or vaccination against B. pseudomallei puts the general population at higher risk. Over 18 years of research at Kasturba Medical College, Manipal helped supplement the understanding of the disease in India. Molecular epidemiology studies revealed that the Indian strains of B. pseudomallei are distinctly different from those found elsewhere.
In our ongoing study, we aim to leverage our expertise and learnings, to develop a phased approach to facilitate a self-sustainable model that incorporates melioidosis into clinical differentials and generates molecular data at an indigenous level. Knowledge obtained from this venture will enable the identification of therapeutic targets and focused drug development pipelines.